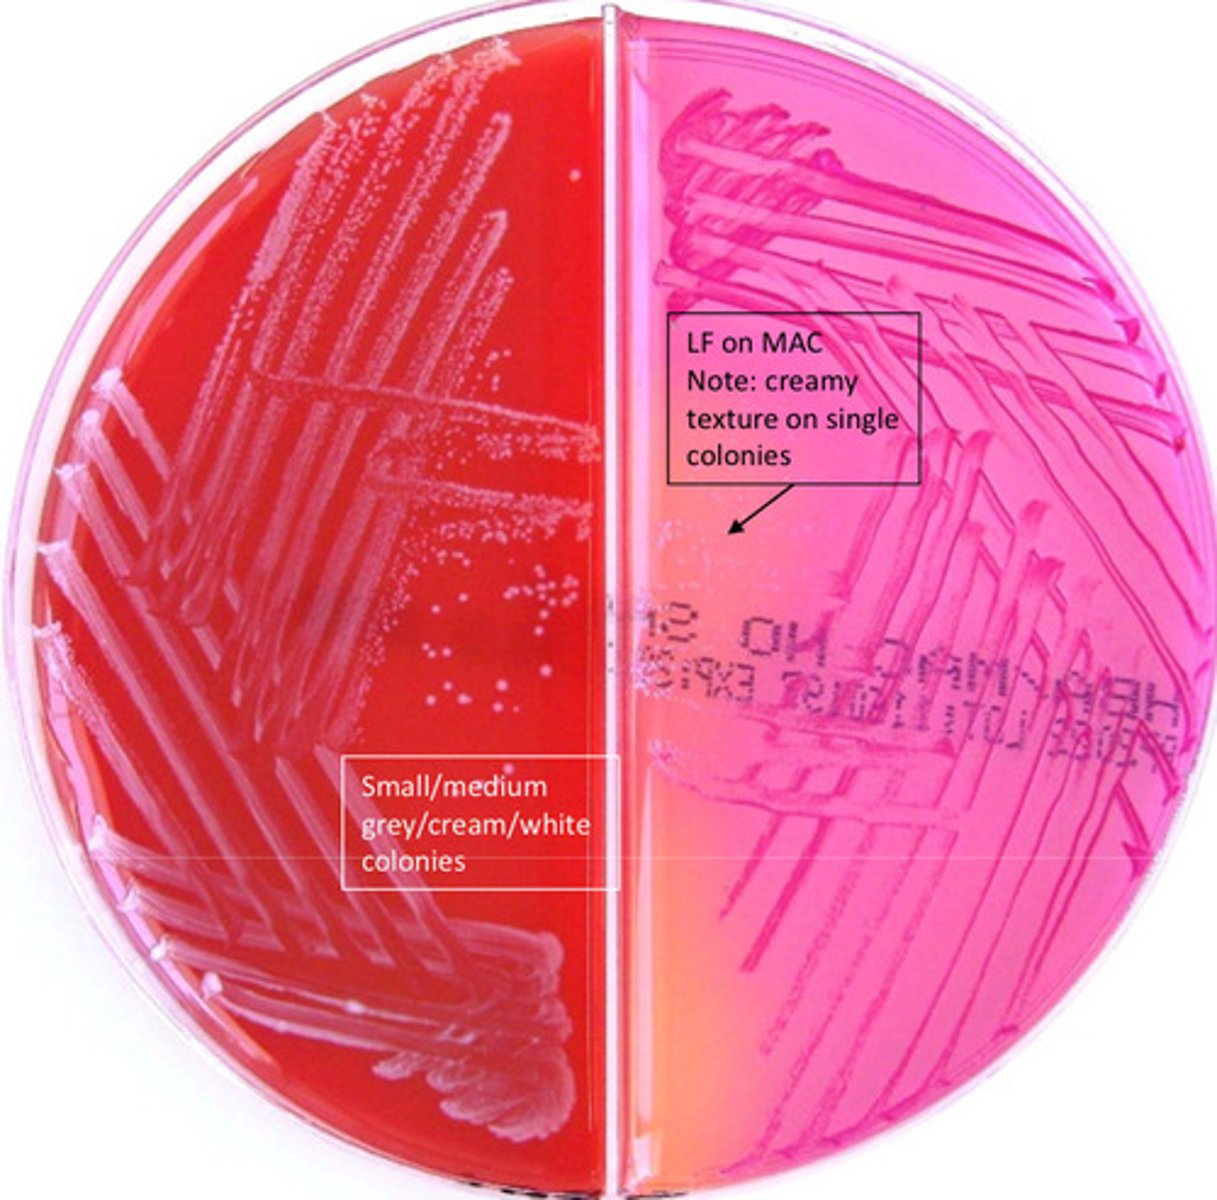
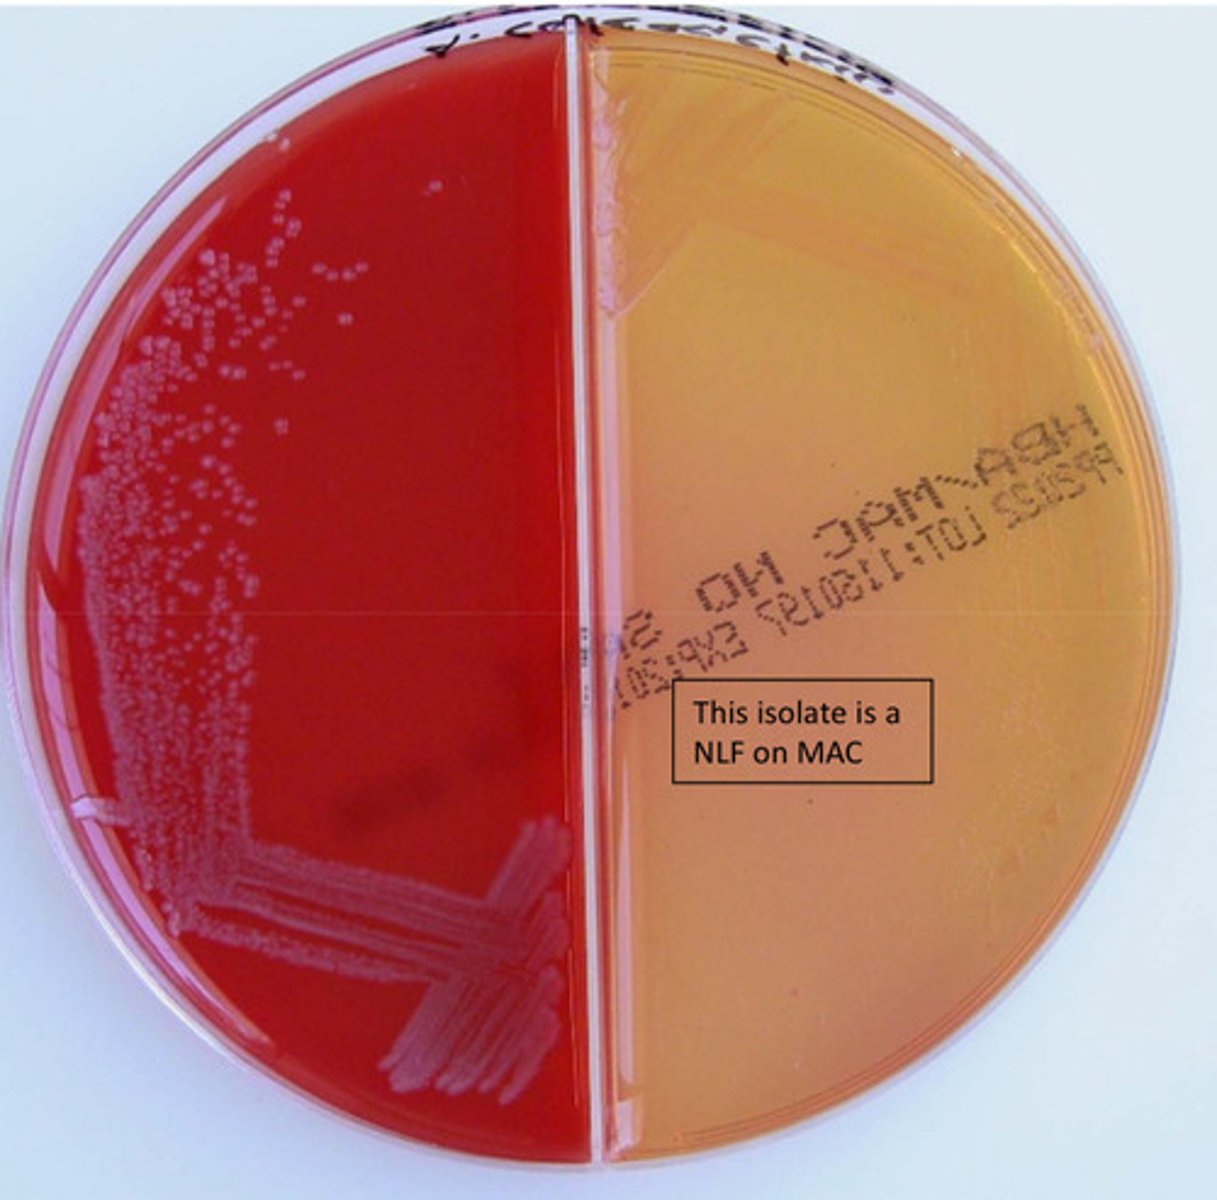
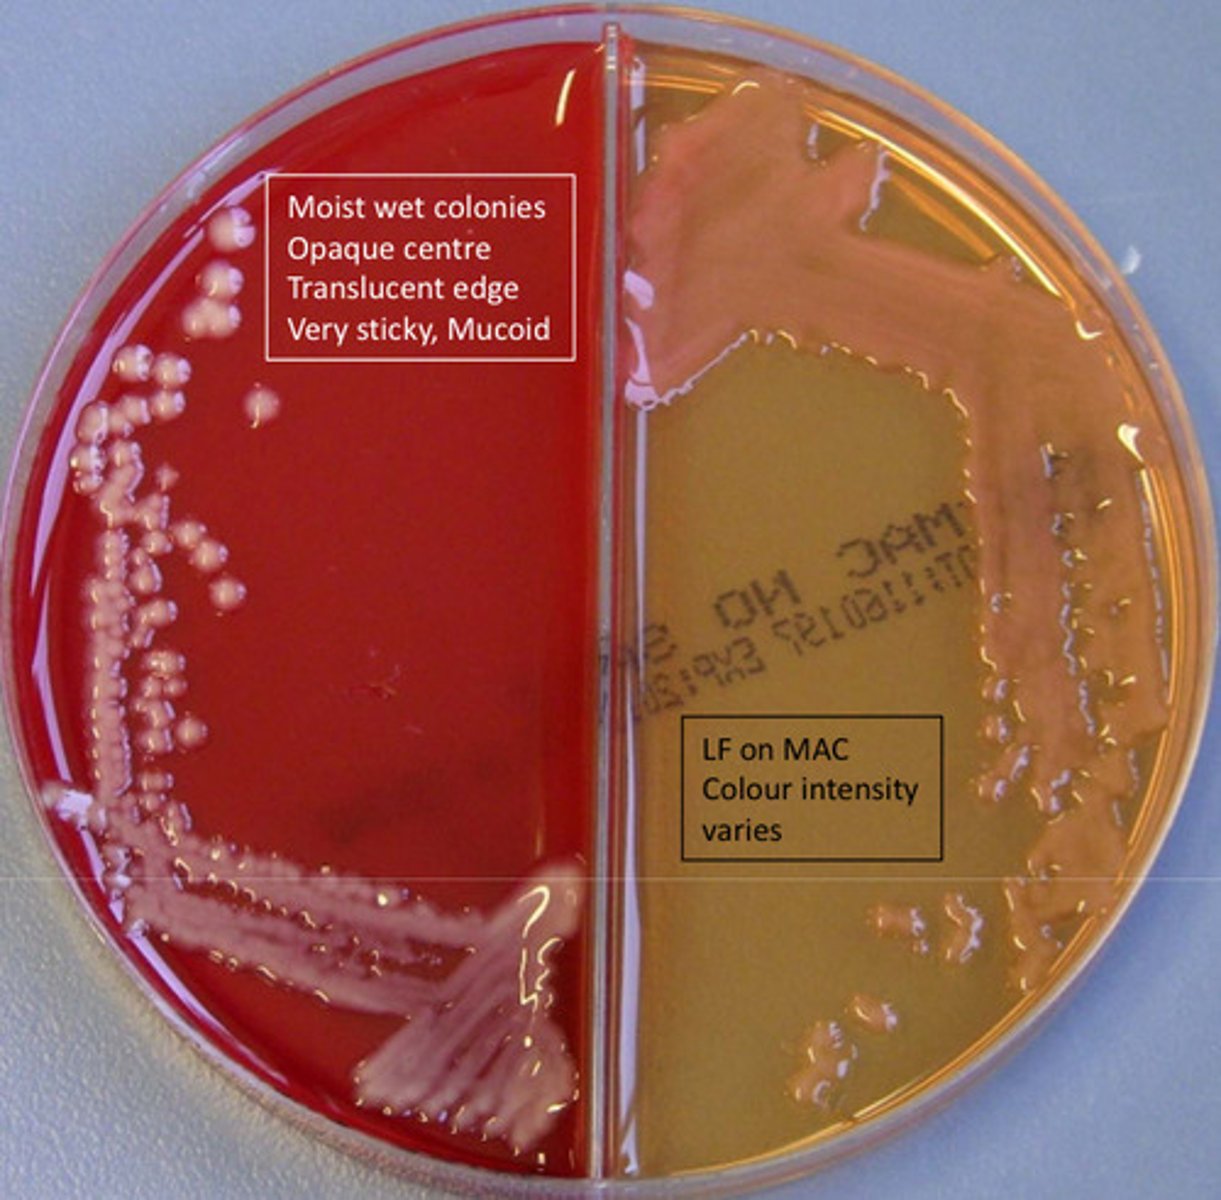

gram positive bacteria’s , gram negative organisms
1/52
There's no tags or description
Looks like no tags are added yet.
Name | Mastery | Learn | Test | Matching | Spaced |
|---|
No study sessions yet.
53 Terms
Bacillus cereus
GPB, catalase pos, beta haemolytic, anaerobic, motile, spores

pink
Positive indole result using Kovac's reagent
blue
Positive indole result using DMACA reagent
Bacillus anthracis
GPB, large rods with spores, catalase pos, lysis with gamma phage, medium large feathered colonies, non motile, non haemolytic anaerobic

Clostridium perfringens
GPB, catalase neg, AnO2 @ 48hrs, double zone haemolysis, obligate anaerobe = sensitive to MTZ, brick shaped, causes gas gangrene

Clostridium tetani
GPB (easily discolourised , alpha or beat haemolytic, obligate anaerobe = sensitive to MTZ, cat neg, swarming, tennis racquet effect

Erysipelothrix rhusiopathiae
GPB, curved rods, cat neg, non motile, H2S pos

Corynebacterium diptheriae
small GPB- pleomorphic, cat pos

Listeria monocytogenes
cat pos GPB (small and pleomorphic), tumbling motility pos, Hippurate pos, palisading appearance

Dermatophilus congolensis
GPB, branching, non-acid fast, cat pos, beta haemolytic, motile

Streptococcus/ enterococcus sp.
GPC, catalase neg

Streptococcus sp.
GPC, catalase neg, arranged in chains, non-motile

Staphylococcus sp.
GPC, catalase pos, arranged in clusters

Streptococcus agalactiae
cat neg GPC, beta haemolytic, group B antigen pos, non motile, Hippurate pos

Streptococcus bovis / equinus complex
GPC, catalase neg, MAC +, group D antigen pos, PYR neg and not 6.5% salt tolerant
Streptococcus pyogenes
GPC, catalase neg, commonly causes tonsillitis, beta haemolytic, group A antigen pos, Bacitracin sens

Enterococcus faecalis
cat neg GPC, lactose pos, PYR pos, Group D pos, mannitol pos, arabinose neg, salt tolerant, common cause of UTI, vancomycin resistant

Streptococcus pneumoniae
catalase neg GPC, alpha haemolytic, bile soluble, optochin sensitive, diplococcus

Staphylococcus aureus
cat pos GPC, coagulase pos

Staphylococcus epidermidis
cat pos GPC, coagulase neg, Novobiocin susceptible (only test urine isolates!), arranged in clusters
Staphylococcus saprophyticus
GPC, catalase pos, found in urine, creamy white colonies, coagulase neg, NV resistant (only test urine isolates), non motile, arranged in clusters

Micrococcus luteus
cat pos GPC (larger than Staph), coagulase neg, obligate aerobe, microdase pos

Acinetobacter baumannnii
GNB, oxidase neg, non-motile, oxidative, amy look like very small diplococci, assacharolytic, can produce purple pigment
Aeromonas hydrophila
GNB, motile, cat pos, oxidase neg, resistant to O10ug and 150ug disc, indole pos, DNAse pos, grows on CIN agar

Plesiomonas shigelloides
GNB, oxidase pos, indole pos, motile, lactose neg, resistant to O129 10ug and susceptible to 150 ug (distinguishes from Aeromonas sp.)
Burkholderia cepacia
GNB, oxidase pos, common in cystic fibrosis patients, spot indole neg, no growth on MAC

Burkholderia pseudomallei
GNB, motile, yellow/green pigment, growth on MAC, resistant to CN

Campylobacter sp.
GNB, oxidase pos, watery teardrop growth, helical/curved bacilli, microaerophilic

Citrobacer freundii
GNB, oxidase neg, motile, spot indole neg

Enterobacter aerogenes
GNB, oxidase neg, motile, lactose fermenter (medium pink), PYR pos

Escherichia coli
GNB, most commonly isolated in urine, catalase positive, oxidase neg, motile, spot indole pos, completely susceptible

Chromobacterium violaceum
GNB, cat pos, violet colonies, indole neg, nitrate pos, DNAse pos

Haemophilus influenzae
GNB, NG on BA/MAC, MH, requires X and V factor for growth

Haemophilus ducreyi
GNB, X factor only = grows on BA, beta haemolytic, school of fish arrangement in gram smear, slightly yellow colonies
Klebsiella pneumoniae
GNB, isolated from a urine, catalase pos, oxidase neg, spot indole neg, non-motile, mucoid colonies
Klebsiella oxytoca
GNB, catalase pos, oxidase neg, non-motile
Pasteurella multocida
GNB, oxidase pos, spot indole pos, NG on MAC, catalase pos

Proteus mirabilis
GNB, from urine sample, catalase pos, oxidase neg, swarming, indole neg, lactose neg, maltose neg

Proteus vulgaris
GNB, catalase pos, oxidase neg, swarming, indole pos, lactose neg, maltose neg
Pseudomonas aeruginosa
GNB, catalase pos, oxidase pos, lactose neg, green pigment, metallic sheen on BA, grape odour, very resistant on sensitivity

Providencia rettgeri
GNB, catalase pos, oxidase neg, indole pos, PYR neg

Serratia marcescens
GNB, red pigment, catalase pos, oxidase neg

Stenotrophomonas maltophilia
GNB, oxidase neg, motile, spot indole neg, resistant to antimicrobials

Salmonella sp.
GNB, enterbacterale, oxidase neg, lactose neg, confirm with serology (Paratyphi A is H2S neg)

Yersinia enterocolitica
GNB, most common GIT pathogen, enterbacterales, oxidase neg, fermentative, PYR pos, use CIN media to isolate, bull's eye colony - dark pink in middle, clear on outside

Shigella sp.
GNB, found in urine and GI, catalase pos, oxidase neg, lactose neg, non-motile

Vibrio alginolyticus
GNB, Beta-haemolytic, oxidase pos, spot indole pos, growth on TCBS- yellow, motile, resistant O129 10ug disk, found in sea water

Moraxella catarrhalis
GNC, hockey puck colonies, capnophilic, oxidase pos, catalase pos

Neisseria gonorrhoea
GNIDC, oxidase pos, catalase pos

Vibrio cholerae
GNB, O1 and O139 serotypes are toxgenic, susceptible O129 10ug disk

Vibrio vulnificus
GNB, found in oysters, susceptible O129 10ug disc, cause necrotising fasciitis in wounds

Neisseria meningitidis
GNC, maltose and glucose pos, growth on CHOC, see intracellularly in PMNs, oxidase pos, catalase pos

Enterobacter cloacae
GNB, lactose pos, catalase pos, oxidase neg, indole neg, quite resistant on sensitivity
